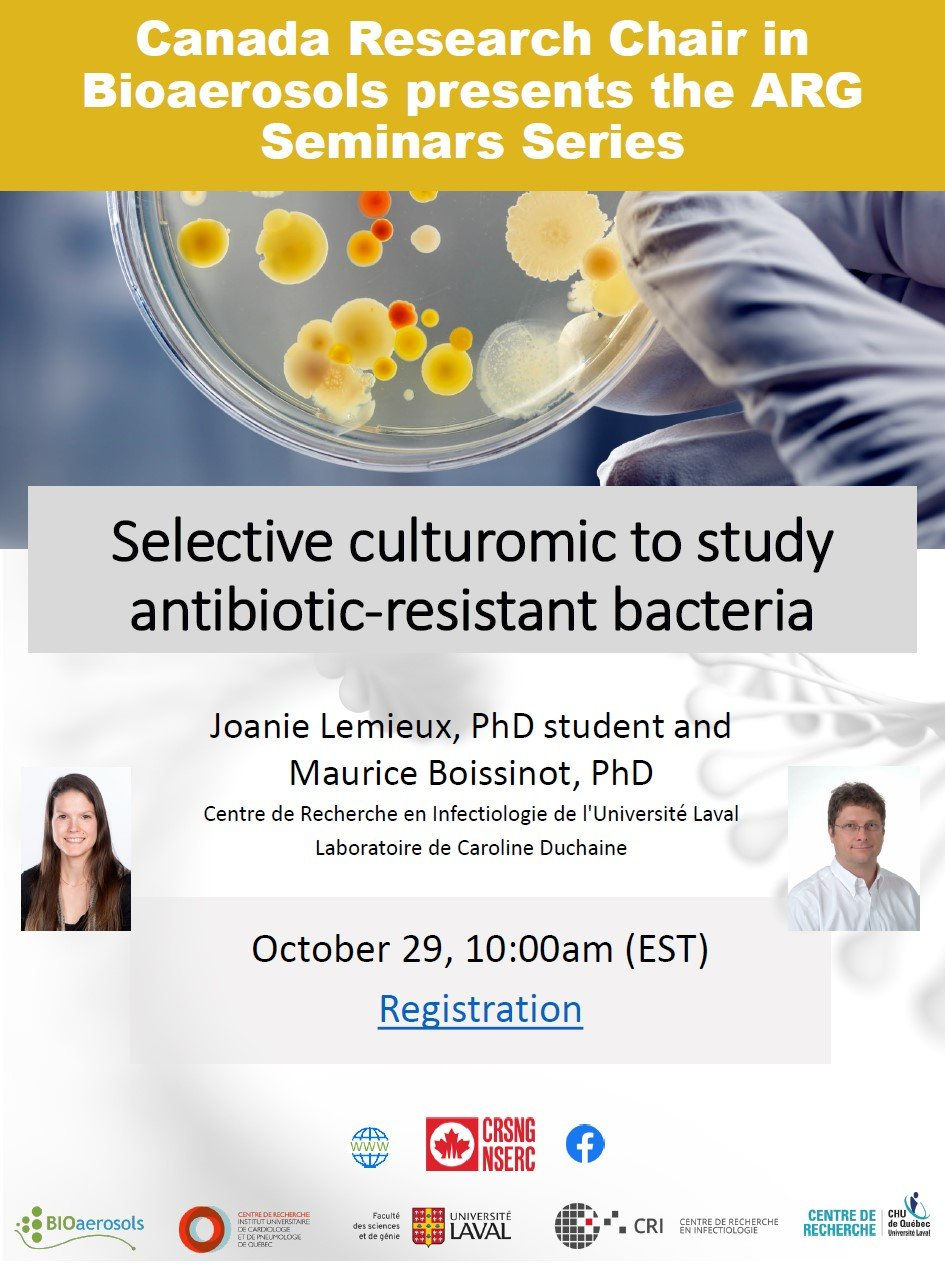
ree

4th Seminar "ARG in bioaerosols"
- 3177416
- Oct 28, 2021
- 1 min read
Updated: Nov 26, 2025
Selective culturomic to study antibiotic-resistant bacteria
The growing popularity of genomic analyzes enable the characterization of different microbiota and the study of their structure. However those high throughput analyzes are not immune from bias. Despite their advantages, these techniques do not allow the study of minority populations and those considered to be unculturable. Selective culture approaches are use to overcome the weaknesses of genomic analyzes.Those culture approaches would be well suited in the study of antibiotic-resistant bacteria in bioaerosols and in the characterization of their resistance genes.
%20(1)%201.png)



Comments